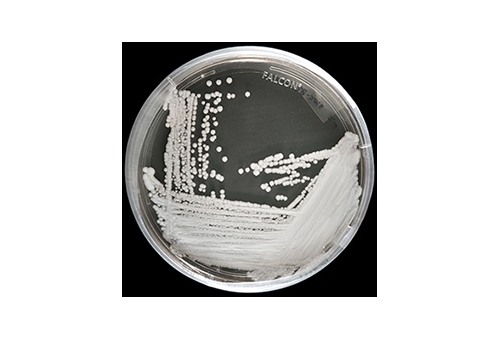

- Medicinal Mushroom Market Size, Demand and Outlook 2019
0评论2019-05-22

- Scientists map global “Internet of Mushrooms”
0评论2019-05-17

- The Race to Cultivate China’s Beloved ‘Zombie Mushroom’
0评论2019-05-16

- Denver Perbolehkan Pemakaian 'Magic Mushroom'
0评论2019-05-15

- Clean Plate column: How to fix morel mushrooms
0评论2019-05-14

- Seeking and finding: Gloria’s Spring mushrooms
0评论2019-05-13

- Denver just voted to decriminalize psychedelic mushrooms
0评论2019-05-09

- Tips for mushroom hunters in Michigan
0评论2019-05-06

- Development plans dampen mushroom grower's future
0评论2019-04-25

- Missouri mushroom hunters are having 'epic' morel season
0评论2019-04-16

- It's time to hit the woods in search of morel mushrooms
0评论2019-04-12

- Missouri’s morel mushroom season may be ‘epic’
0评论2019-04-09
- A deadly drug resistant fungus threatens the world
0评论2019-04-08

- Does eating mushrooms protect brain health?
0评论2019-04-01
Researchers Now Say Mushrooms May Reduce Risk Of Cognitive Decline
Maybe all mushrooms are magic. Just weeks after scientists tell us the psychedelic ones could one day be used to treat d
0评论2019-03-26

- Eating mushrooms may slow mental decline: Study
0评论2019-03-14













